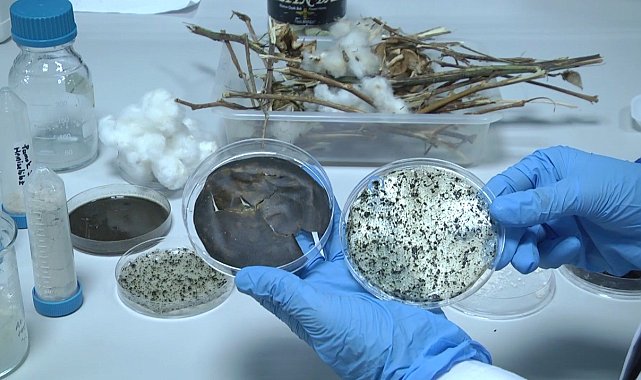

Şanlıurfa'da 2 üniversite öğrencisi örnek bir projeye imza atarak atık alglerden yüzde 100 doğada çözülebilen biyoplastik hammadde üretti. Öğrenciler yaptıkları projeleriyle ödül aldı.
Harran Üniversitesi Fen-Edebiyat Fakültesi Moleküler Biyoloji ve Genetik Bölümü yüksek lisans öğrencisi Ümmühan Şaş ile lisans öğrencisi Bengü Kelender'den oluşan "AlgPack" takımı, Türkiye'nin 86 farklı üniversitesinden 2 bin 37 öğrencinin katıldığı İnovaTim İnovasyon yarışmasında, üçüncü olarak dereceye girdi. Harran Üniversitesi öğrencileri, 686 takım içerisinden ilk 10 takım arasına girerek, tüm etapları başarıyla geçti. Yarışmada elde ettikleri başarı ile 60 bin liralık ödülün sahibi olan öğrenciler, projelerini yatırımcılara sunabilme imkanına da sahip oldu. Danışmanlığını Fen- Edebiyat Fakültesi Dekanı Prof. Dr. Yusuf Kurt'un yaptığı projede, atık alglerden yüzde 100 doğada çözülebilen biyoplastik hammadde elde edilmesi ve farklı polimerlerle karışım yaparak plastik kullanılan birçok alanda değerlendirilmesi hedefleniyor.
Genç girişimci öğrenciler, 'Atık alglerden yüzde 100 doğada çözülebilen biyoplastik hammadde elde edilmesi ve farklı polimerlerle karışım yaparak plastik kullanılan birçok alanda değerlendirilmesi' projesi, Türkiye İhracatçılar Meclisinin düzenlediği yarışmada dereceye girdi. Burada derece yapan öğrenciler, dünyanın birçok ülkesinden üniversitelerin katılacağı Ürdün'de düzenlenecek olan yarışmaya katılmaya hak kazandı.
"Doğada bin 200 yılda çözülebilen hammaddeyi 80 ile 100 yıla düşürüyoruz"
Harran Üniversitesi Moleküler Biyoloji ve Genetik Bölümünde Yüksek Lisans Öğrencisi Ümmühan Şaş, "Dünya genelinde plastik kirliliği ciddi bir sorun her yıl 400 bin ton atık plastik oluşuyor. Bunun sadece yüzde 9'luk kısmı dönüştürebilirken yüzde 79'lük kısmı geriye dönüştürülmeden çöplerde imha ediliyor. Bunlar ya yakılarak yada toprağa karıştırılarak bir şekilde imha ediliyor. Bu rakamları Türkiye'ye entegre ettiğimizde Türkiye Akdeniz'e, Mısır ve İtalya'dan sonra plastik atık bırakan üçüncü ülke konumundadır. Peki biz niye üçüncü ülkeyiz diye baktığımızda bilinçsiz toplum, geri dönüşüm tesislerinin yetersizliği yada kullanılan kimyasalların zararları gibi nedenler bizi üçüncü ülke konumuna itmektedir. Biz 'AlgPack' ekibi olarak doğada yüzde 100 çözülebilen biyoplastik hammaddesi üretiyoruz. Bunları da yaparken atık olarak atılan algleri kullanıyoruz. Belediyeler tarafından yaz ve ilkbahar aylarında bu algler, yosunlar toplanıyor ve atılıyor. Biz de diyoruz ki atmayın bize verin bunlardan geri dönüştürülebilir biyoplastik hammaddeler üretelim ve bu şekilde aslında polimerlere katılarak polimerlerin doğada çözülme yüzdesini arttırmayı hedefliyoruz. Normal bir polimer doğaya atıldığı zaman çözülme süresi bin 200 yıl iken biz bunu yüz yıla seksen yıla düşürmeye hedefliyoruz. Polimerin çözülme hızını hedefliyoruz evet polimerler doğada, denizde toprakta çözülmüyor. Bizim hammaddemizi polimer üreten şirketler alarak kendi hammaddelerine kattığı müddetçe polimerin doğa çözülme hızını arttıracaklar. Bin 200 yılda çözülmeyecekte bizim verdiğimiz oranlara göre yüz yılda, 200 yılda daha hızlı çözülme elde edecekler ve bu şekilde doğada bin 200 yılda kaybolan plastik 50 yılda, 100 yılda çözülebilecek. Biz projemizi genç girişimciler fikir maratonunda duyurduk ve Türkiye ikinciliği elde ettik. Şuanda Ürdün'de düzenlenecek olan global yarışmasındayız. Onun sonucunu bekliyoruz. İhracatçılar Birliğinin (TİM) Türkiye İnovaTim İnovasyon Week'e katıldık orada üçüncü olduk bu şekilde destekler geliyor. Bizim de amacımız bu destekleri alarak daha ileriye gitmek" dedi.
Harran Üniversitesi Moleküler Biyoloji ve Genetik Bölümü lisans son sınıf öğrencisi Bengü Kelender ise, "Bunu yaparken özelikle polimerlerin doğada çözülme yüzdesine bakarak yola çıkıyoruz yani bir polimer doğada uzun yıllar kalabiliyor. Toprağa büyük zararları mevcut, bunu mikroorganizmalar yediklerinde de vücutlarında büyük kalıntılara sebep olabiliyor. Bunların yüzünden ölen kuşlar deniz kaplumbağaları, deniz memelileri bir ton canlı var sadece plastik atığından ölen bunları daha biyobozulur forma getirdik. Bunu da hammaddeyi atık yosunlardan, atık pamuklardan gliserolden elden ediyoruz. Atık yosun dediğimiz, özellikle İzmir'de körfez kıyı belediyelerinden temin ediyoruz. Bunlar müsilajla beraber gün yüzüne çıkıyor ve çok kötü kokuyorlar, belediyelerde bunları toplayarak ve çöp olarak tekrar atıyorlar. Biz bu çöpleri belediyelerden temin ediyoruz, Urfa'ya getiriyoruz. Bazı işlemlerden geçiriyoruz, ardından sadece elimizde yosun kalıyor. Bu yosunu bir arada tutabilmek ve plastik yapabilmek için bir kıvam artırıcıya ihtiyaç var. Şanlıurfa'da okuyoruz, Harran ovası bunun için mükemmel bir yer. Pamukları ve mısırları kullanıyoruz. Bunların içindeki selüloz oranı çok fazla selülozda en iyi kıvam artırıcılardan biri nişasta ile beraber. Biz selülozu tercih ettik, elimizde o ürün vardı bununla beraber tekrar kattıktan sonra içerisine nano selüloz boyutuna getirdik. Çünkü yapısını çok küçültürseniz bir şeyin boyutunu tanecik boyutunu yüzey alanı çok genişler ve bir arada durma mukavemeti daha da artar. Nano selülozların özellikle selüloz yapılı maddelerin su geçirgenliği de daha azdır bu yüzden bunu tercih ettik. Hem atık yosunlarımız hem nano hem selülozumuzu bir araya getirerek bir de gliserolumuzu şeker formunu eklediğimizde bize bir plastik oldu ve bu plastiği özellikle granür halde dökerek var olan polimerlere entegre ettiğimizde de biyobozunurluk yüzdesini arttırıyoruz. Bir markete gittiğimizi varsayalım markete gittiğinizde aldığınız 25 kuruşluk o plastikler doğada bin 200 yılda çözünüyorlar. Yani sizden sonraki en iyi ihtimalle 12 nesil sizin çöpünüzü görüyor. Biz istiyoruz ki sizden sonraki nesillere böyle şeyler bırakmayın da daha güzel şeyler bırakın bilgi gibi, birikim gibi, bilim gibi çöpten ziyade. O yüzden siz yaşarken çöpünüzün özellikle doğada kaybolması asıl hedefimizdir. Biz, Genç Girişimciler Fikir Maratonuna katıldık Gaziantep'te birinci olduk, ardından Ankara'da yapılan Demo Day gününde ikinci olduk. İlk iki takım Global'e çıkıyor. Ürdün'de global bir yarışma var, oraya evraklarımızı gönderdik sonucunu bekliyoruz. Umarım orada da dereceye gireriz" ifadelerini kullandı.
İHA

Yorumlar
Kalan Karakter: